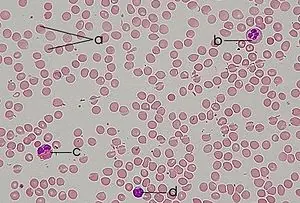

Envía dinero por Internet a México de manera rápida por tan solo $4.99
www.xoom.com
La Histología es la ciencia que estudia todo lo referente a los tejidos orgánicos: su estructura microscópica, su desarrollo y sus funciones. La histología se identifica a veces con lo que se ha llamado anatomía microscópica, pues su estudio no se detiene en los tejidos, sino que va más allá, observando también las células interiormente y otros corpúsculos, relacionándose con la bioquímica y la citología.

_ Tejido epitelial: El epitelio es el tejido formado por una o varias capas de células unidas entre sí que puestas recubren todas las superficies libres del organismo, y constituyen el revestimiento interno de las cavidades, órganos, huecos, conductos del cuerpo y la piel y que también forman las mucosas y las glándulas. Los epitelios también forman el parénquima de muchos órganos, como el hígado.
Mas info: http://es.wikipedia.org/wiki/Epitelio

_ Tejido conectivo: Así entendidos, "los tejidos conjuntivos" concurren en la función primordial de sostén e integración sistémica del organismo. De esta forma, el TC participa de la cohesión o separación de los diferentes elementos tisulares que componen los órganos y sistemas; y también se convierte en un medio logístico a través del cual se distribuyen las estructuras vásculonerviosas.

Con criterio morfofuncional, los tejidos conjuntivos se dividen en dos grupos:
Tejido conectivo no especializado:
_ Tejido conectivo laxo: (es siempre irregular)
_ Tejido conectivo mucoso o gelatinoso
_ Tejido conjuntivo reticular
_ Tejido mesenquimal
_ Tejido conectivo denso:
_ Tejido conectivo denso regular
_ Tejido conectivo denso irregular.
Tejidos conectivos especializados:
_ Tejido adiposo
_ Tejido cartilaginoso
_ Tejido óseo
_ Tejido hematopoyético
_ Tejido sanguíneo (sangre)
Tejido conectivo no especializado:
_ Tejido conectivo laxo: El TC laxo se caracteriza porque la presencia de células y componentes extracelulares de la matriz en proporción es más abundante que los componentes fibrilares.
_ Tejido conectivo mucoso o gelatinoso: Es un tejido conectivo laxo en el que predomina la sustancia fundamental amorfa compuesta por ácido hialurónico. La celularidad es media, principalmente fibroblastos y macrófagos, irregularmente dispersos en la matriz jaleosa.
No es frecuente penetrar este tipo de tejido en el adulto, pero sí en el cordón umbilical del recién nacido, un material conocido como Gelatina de Wharton; también en la pulpa de los dientes en escasa cantidad.

_ Tejido conjuntivo reticular: El tipo reticular de TC laxo se caracteriza porque abundan las fibras reticulares argirófilas, compuestas por colágeno de tipo III. Dan un aspecto de entramado de red tipo malla, en el que se distribuyen los fibroblastos esparcidos por la matriz. El TC reticular compone la estroma de la médula ósea, el bazo, los ganglios linfáticos y el timo, dando sustento y armazón microclimático al parénquima.

_ Tejido mesenquimal: El tejido mesenquimal compone el mesénquima embrionario, o la totalidad de los tejidos conectivos diferenciados y en diferenciación en el embrión. Estos tejidos primariamente tienen una consistencia laxa y son ricos en células mesenquimales que por diferenciación aportan células específicas para cada tipo de tejido maduro.

_ Tejido conectivo denso:El tejido conectivo denso puede adoptar dos tipos básicos de configuraciones:
_ Tejido conectivo denso regular: Es el tipo de TC que forma los tendones, aponeurosis, ligamentos y en general estructuras que reciben tracción en la dirección hacia la cual se orientan sus fibras colágenas.
_ Tejido conectivo denso irregular: Básicamente se encuentra formando la cápsula de todos los órganos a excepción del páncreas que es un tejido conectivo aerolar laxo. En este tejido conectivo denso irregular encontraremos fibras de colágeno dispuestas en una forma aleatoria, y muy poca sustancia fundamental. Esto proporciona protección contra el estiramiento excesivo de los órganos ya mencionado.
Tejidos conectivos especializados:
_ Tejido adiposo: El tejido adiposo o tejido graso es el tejido de origen mesenquimal (un tipo de tejido conjuntivo) conformado por la asociación de células que acumulan lípido en su citoplasma: los adipocitos.
El tejido adiposo, por un lado cumple funciones mecánicas: una de ellas es servir como amortiguador, protegiendo y manteniendo en su lugar los órganos internos así como a otras estructuras más externas del cuerpo, y también tiene funciones metabólicas y es el encargado de generar grasas para el organismo.
_ Tejido cartilaginoso: El tejido cartilaginoso o simplemente cartílago, es un tipo de tejido conectivo altamente especializado, formados por células condrógenas (condrocitos y condroblastos), fibras colágenas, elásticas y matriz extracelular. El tejido cartilaginoso es parte del páncreas embrionario. Se le llama cartílago a las piezas formadas por tejido cartilaginoso. Es un tejido que no posee vasos sanguíneos, nervios ni vasos linfáticos.
_ Tejido óseo: El tejido óseo es un tipo especializado de tejido conectivo, constituyente principal de los huesos en los vertebrados. El tejido óseo está compuesto por células y componentes extracelulares calcificados que forman la matriz ósea. Se caracteriza por su rigidez y su gran resistencia tanto a la tracción como a la compresión.
_ Tejido hematopoyético: El tejido hematopoyético es el responsable de la producción de células sanguíneas. Existe tejido hematopoyético en el bazo, en los ganglios linfáticos, en el timo y, fundamentalmente, en la médula ósea roja, el centro hematopoyético más importante del organismo. En el momento de nacer, toda la médula ósea es roja. En los individuos adultos, la médula roja persiste en los intersticios de los huesos esponjosos. Se trata de un tejido blando, formado por fibras reticulares y una gran cantidad de células: adiposas, macrófagos, reticulares y precursoras de las células sanguíneas.
_ Tejido sanguíneo (sangre): La sangre (humor circulatorio) es un tejido fluido que circula por capilares, venas y arterias de todos los vertebrados e invertebrados. Su color rojo característico es debido a la presencia del pigmento hemoglobínico contenido en los eritrocitos.
Es un tipo de tejido conjuntivo especializado, con una matriz coloidal líquida y una constitución compleja. Tiene una fase sólida (elementos formes, que incluye a los glóbulos blancos, los glóbulos rojos y las plaquetas) y una fase líquida, representada por el plasma sanguíneo.
a: Glóbulos rojos o eritrocitos
b: Glóbulo blanco: Neutrófilo
c: Glóbulo blanco: Eosinófilo
d: Glóbulo blanco: Linfocito

_ Tejido nervioso
Las células del sistema nervioso se dividen en dos grandes categorías: neuronas y células neurogliales.
_ Neurona: Tienen un diámetro que va desde los 5nm a los 150nm son por ello una de las células más grande y más pequeña a la vez.La gran mayoría de neuronas están formadas por tres partes: un solo cuerpo celular, múltiples dendritas y un único axón. El cuerpo celular también denominado como pericarión o soma, es la porción central de la célula en la cual se encuentra el núcleo y el citoplasma perinuclear. Del cuerpo celular se proyectan las dendritas, prolongaciones especializadas para recibir estímulos de células sensoriales, axones y otras neuronas. Y por último el axón, una prolongación de longitud variable y hasta 100 cm de largo, que suelen tener dilataciones conocidas como terminales del axón, en su extremo cerca de él.
_ Células gliales: Son células no nerviosas que protegen y llevan nutrientes a las neuronas. Glia significa pegamento, es un tejido que forma la sustancia de sostén de los centros nerviosos. Está compuesta por una finísima red en la que se incluyen células especiales muy ramificadas.
Se divide en:
Glia central. Se encuentra en el SNC (encéfalo y médula):
_ Astrocitos
_ Oligodendrocitos
_ Microglía
_ Células Ependimarias
Glia Periférica. Se encuentra en el SNP ( ganglios nerviosos, nervios y terminaciones nerviosas):
_ Células de Schwann
_ Células capsulares
_ Células de Müller
_ Tejido muscular
Hay tres tipos de tejidos musculares clasificados con base en factores estructurales y funcionales. En el aspecto funcional, el músculo puede estar bajo control de la mente (músculo voluntario) o no estarlo (músculo involuntario). En lo estructural, puede mostrar bandas transversales regulares a todo lo largo de las fibras (músculo estriado) o no presentarlas (músculo liso o no estriado). Con base a esto los tres tipos de músculo son:
_ Músculo estriado voluntario o esquelético: Insertado en cartílagos o aponeurosis, que constituye la porción serosa de los miembros y las paredes del cuerpo. Está compuesto por células "multinucleadas" largas (hasta 30cm) y cilíndricas que se contraen para facilitar el movimiento del cuerpo y de sus partes.
_ Músculo Cardíaco: Se forma en las paredes del corazón y se encuentra en las paredes de los vasos sanguíneos principales del cuerpo. Deriva de una masa estrictamente definida del mesenquima esplácnico, el manto mioepicardico, cuyas células surgen del epicardio y del miocardio. Las células de este tejido poseen núcleos únicos y centrales aunque algunas células pueden contener hasta dos núcleos, también forman uniones terminales altamente especializadas denominadas discos intercalados que facilitan la conducción del impulso nervioso.

_ Músculo liso involuntario: Se encuentra en las paredes de las vísceras huecas y en la mayor parte de los vasos sanguíneos. Sus células son fusiformes y no presentan estriaciones, ni un sistema de túbulos T. Son células mononucleadas con el núcleo en posición central.

Y por ultimo y no menos importante, me sirvió mucho este pequeño atlas que hizo la UBA con fotografias de microscopia optica de preparados de MEDICINA HUMANA.. no hay grandes diferencias con las de un carnívoro por lo que me fue de mucha utilidad...
preparados 4x 10x 16x y 40x de todos los tejidos corporales.. recomendado...
click en el link para verlo en grande
link: http://www.fmv-uba.org.ar/grado/medicina/ciclo_biomedico/primer_a%F1o/histologiasp/1ra/v3/Atlas.swf